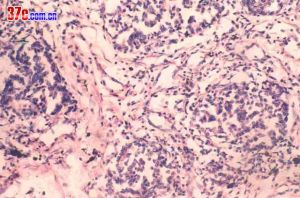
肺炎性假瘤

疾病簡介
 肺炎性假瘤
肺炎性假瘤臨床上肺炎性假瘤並不常見,男女均可發生,患者年齡從1~70歲,但年輕人多見,大多在30歲左右。今一半的病人無症狀,其餘可有肺及胸部的有關症狀,如咳嗽、咯血、呼吸短促及胸痛。有的可有發熱。病變可發生於任何肺葉,X線常表現為孤立的、界限清楚的圓形或卵圓形包塊。較大者腫塊界限不清,偶見鈣化或空洞形成。
 肺炎性假瘤
肺炎性假瘤大體實性結節狀,位於肺周邊實質內,也可見於氣管或大支氣管內,有的可占據整個肺葉,有時可擴展至縱隔、胸內筋膜或橫膈。類似病變也有發生在葉間裂者。
鏡下:實性包塊,肺之基本結構消失,在包塊的邊緣部分見病變向鄰近的肺實質的間質擴展,使有些肺泡或細支氣管散在其中;肺泡上皮增生明顯,肺泡間隔內由成團成片的來源不明的腫瘤細胞占據,瘤細胞可有異型性、分裂像。間質可見增生、透明性變,其中的腫瘤細胞表現呈“浸潤性”生長。
此瘤的生物學行為為良性,手術切除即治癒,如切除不完全亦可繼續增大。一般預後良好。
病因
 肺炎性假瘤
肺炎性假瘤肺炎性假瘤一般位於肺實質內,累及支氣管的僅占少數。絕大多數單發,呈圓形或橢圓形結節,一般無完整的包膜,但腫塊較局限、邊界清楚,有些還有較厚而缺少細胞的膠原纖維結締組織與肺實質分開。
少數肺炎性假瘤可以發生癌變。
臨床表現
肺炎性假瘤患者多數年齡在50歲以下,女性多於男性。1/3的患者沒有臨床症狀,僅偶然在X線檢查時發現,2/3的患者有慢性支氣管炎、肺炎、肺化膿症的病史,以及相應的臨床症狀,如咳嗽、咳痰、低熱,部分患者還有胸痛、血痰,甚至咯血,但咯血量一般較少。
肺炎性假瘤的診斷存在一定的困難,患者的臨床症狀較難與慢性支氣管炎及肺部惡性腫瘤鑑別。胸部X線檢查為圓形或橢圓形,邊緣光滑銳利的結節影,有些邊緣模糊,似有毛刺或呈分葉狀,與肺癌很難鑑別。肺炎性假瘤在肺部無明確的好發部位,大小可以從1cm到16cm,多數在4cm以下。這些都給診斷造成困難。
診斷
 肺炎性假瘤
肺炎性假瘤多有呼吸道感染病史,可無臨床症狀或有間歇發作的發熱、咳嗽、喀痰等表現,偶有咯血。
二.體檢發現:
多數無陽性體徵,有呼吸道感染時,可有發熱,肺部聽診有乾或濕性羅音。
三.輔助檢查:
胸部X線片及CT掃描,有直徑1~6cm圓或橢圓形孤立塊影,中等密度,質地均勻,邊緣不甚清楚,少數可有胸膜粘連影,多數在肺的外周.診斷有困難或不能除外惡性者,應行開胸或經胸壁肺活檢。
四.鑑別診斷:
應與肺癌及其他良性肺腫瘤鑑別。
檢查
 肺炎性假瘤
肺炎性假瘤肺炎性假瘤可發生在兩肺的任何部位。本組右上肺(12/20)多於左上肺(2/10)的假瘤,多位於下葉背段和內後基底段。球型瘤體一般邊緣光滑銳利,直徑多在1~4 cm,密度比較均勻,周圍肺野清晰。團塊樣的瘤體一般境界不清,邊緣模糊。部分病灶密度濃淡不勻,如多次並發急性炎症可造成“瘤”影擴大,在其周圍恰似炎性浸潤的片狀影。因此假瘤邊緣清楚與否取決於腫塊周圍的病理變化。境界面清楚者,瘤體周圍一般有假性包膜,若病灶處於急性階段時,假瘤周圍顯示炎性,滲出在瘤體周圍多呈模糊影亦無假包膜形成。
2、CT檢查
CT圖像把假瘤與肺的境界面顯示得非常清楚,即使胸片表現為大片狀或團塊狀模糊影,但在CT圖像上則表現為境界清楚的塊影。CT掃描比胸部平片更容易發現小空洞的存在,這種小空洞可以單發,也可以多發。除此以外,CT圖像上顯示腫塊周圍長毛刺胸膜增厚粘連征像對本病診斷有著重要意義。
3、纖維支氣管鏡經皮肺穿刺和術中冰凍病理檢查對本病的診斷和鑑別診斷有非常重要的意義。
治療措施
有呼吸道症狀者,給予抗感染治療,難以鑑別良惡性的病變,宜儘早手術切除。
由於肺炎性假瘤術前很難確切診斷尤其難與肺癌區別,又偶有癌變的可能,因此一般主張及早手術。術間可以根據探查所見作出初步判斷,必要時送病理冰凍切片檢查,以明確診斷。確定良性性質後,手術以儘量保存正常肺組織為原則。處於肺表面的炎性假瘤,不難剔除。位於肺實質內的炎性假獎罰軻以行局部楔形切除或肺段切除,除巨大腫塊及已侵及支氣管的以外,一般不做肺葉及全肺切除。手術預後良好。
CT表現
肺炎性假瘤
肺炎性假瘤1、 材料與方法
總結近年來經手術病理證實的肺炎性假瘤10例,其中男4例,女6例,年齡19~62歲。臨床表現有咳嗽6例,咯血或痰帶血絲5例,病初發熱4例,胸痛或胸悶不適4例,病史最長為3年余。實驗室檢查血常規2例白細胞計數及中性分類升高,其餘均在正常範圍。
CT機為德國西門子SOMATOM AR.C,掃描層厚、間隔各10mm,病灶局部加5mm薄層掃描。5例為平掃加增強,2例為直接增強,3例僅做平掃。
2 、結果
2.1 病灶分布 兩肺上葉2例;中葉與舌葉2例;兩肺下葉5例;跨葉病灶1例為右下葉背段與上葉後段的腫塊。位於肺外周6例,所有病例均為單發。
2.2 大小與密度 腫塊直徑1.5~8cm之間,其中≤3cm4例,≥6cm5例。密度不均勻或不均勻強化6例,平掃CT值25~45Hu,增強掃描CT值45~86Hu。病灶內有散在斑片狀鈣化1例。
2.3 形態
2.3.1 浸潤型 3例,表現為楔形、類三角形高密度影,中央濃集呈團塊狀,邊緣模糊不清,近肺門側可見引流支氣管影,外側緣有粗條索狀影向外延伸,近胸膜者可見有胸膜粘連。
2.3.2 腫塊型 形態不規則3例,類圓形邊緣光滑6例。其中分葉2例;有粗毛刺4例;腫塊周圍有薄片狀、格線狀改變5例;平直征2例;桃尖征2例;內側緣引流支氣管影4例;腫塊內小空泡或支氣管影3例;胸膜增厚、粘連3例。所有病例CT檢查均未見縱隔淋巴結腫大。
3 、討論
肺炎性假瘤發病率較低,有報導僅占肺和支氣管腫瘤的0.7%,在肺良性腫塊中次於結核球居第二位。可發生於任何部位、任何年齡,以女性多見。國外文獻顯示平均年齡28歲,國內報導平均年齡偏大,為50歲左右。
肺炎性假瘤病因尚不十分清楚,多數學者認為系細菌病毒感染後非特異性炎症的機化、修復而引起的局限性瘤樣慢性增生性病變,形成的腫塊壓迫周圍肺組織或周圍肺組織反應性改變,形成假性包膜,所以一般邊界光整。少數包膜不完整、無包膜或有胸膜粘連者,邊緣可不光整。在病理上依其主要的細胞成分分為組織細胞瘤型、硬化性血管瘤型、漿細胞肉芽腫型、細胞上皮乳頭樣增生型和假性淋巴瘤五個類型。根據影像學表現可分為浸潤型和腫塊型,但病理上分類與影像學改變沒有必然的聯繫。
肺炎性假瘤好發於中下肺葉和肺外周部分,也可跨段或跨葉。Agrons報導發生於肺下葉占 61%(31/61)。本組發生於中(舌)下肺葉為(7/10),肺外周部分為(6/10),符合炎性假瘤源於慢性炎症的解剖生理特點。因此也可以認為浸潤型、腫塊型包括形態不規則形和類圓形邊緣光滑者,是肺炎性假瘤的整個病理髮展過程的表現。
浸潤型是肺炎實變基礎上不能完全吸收而出現組織增生,病變範圍縮小,密度增高,其中心呈團塊狀,周圍纖維索條狀影增多並向外延伸。偽足征指腫塊邊緣由二處發生粗索條影匯合成單一細長線影,其基底寬,呈狹長三角形,形如偽足,尖峰常與胸膜粘連。但與肺癌“V”形胸膜凹陷征不同,後者沒有自塊影二處發出後匯合的表現。此型因有較多滲出實變及周圍粗索條影,一般與肺癌易於區別。
腫塊型是隨著病變的局限化,周圍滲出的吸收,腫塊趨向明顯,形態不規則,包膜形成後邊緣則光滑銳利。其與肺癌腫塊形成機理完全不同,前者為炎症的局限化,向心性濃縮成塊。後者為向外進行性增大的過程。尋找炎症的跡象是區別二者的關鍵。
本組3例表現為腫塊的某一部分邊緣平坦形如刀切或呈方形,稱平直征或方形征,具有特異性,可能為炎性腫塊的肺段與肺葉的邊界。腫塊形態不規則和分葉在病理上觀察發現為不同組織、不同數目的細胞群以及不同程度增生形成,相反邊緣光滑圓形腫塊為同類組織以同等增生程度形成。假瘤的分葉一般較淺或沒有分葉,但有作者認為分葉的深淺不能作為與肺癌鑑別的依據。桃尖征指腫塊某一邊緣尖角狀突起形似桃尖,崔允峰認為是炎性假瘤包膜的粘連牽拉,為良性腫塊尤其是炎性假瘤特有。本組有2例病灶邊緣有尖角樣粘連帶即所謂的“桃尖征”。病灶內鈣化少見,Agrons統計占15%,認為是本病的特徵,尤其是兒童與青少年,發現伴有鈣化的腫塊首先要想到本病的可能。其鈣化常呈廣泛散在斑點狀、密集狀、弧形或毛絮狀。增強後腫塊常有明顯的強化。
腫塊近肺門側引流支氣管影、周邊暈圈樣改變和格線狀改變及無肺門和縱隔淋巴結腫大等都有助於與肺癌鑑別。CT隨訪複查有助於病灶的動態觀察,提高診斷的準確性,但仍需結合其他各種檢查綜合分析以避免誤診。
影像學表現
 肺炎性假瘤
肺炎性假瘤X線表現:假瘤可發生在肺的任何部位,球型瘤體由於有較完整的假性包膜,因此輪廓清楚,邊緣光滑,周圍肺野清晰。團塊狀的瘤體由於假包膜不完整,一般境界不清,邊緣模糊,部分病灶密度濃淡不勻,如多次並發急性炎症,可造成“瘤”影擴大,在其周圍恰似炎性浸潤的片狀影。崔氏報導的“桃尖征”本組出現率不高,其病理基礎可能是一種腫瘤包膜粘連的徵象;CT表觀:CT圖像把假瘤與肺的界面,特別是假瘤的邊緣、密度、空洞、長毛刺影與胸膜粘連等顯示得非常清楚。本文36例胸部平片僅2例見有空洞影,而25例CT掃描發現9例小空洞,這種空洞可以單發也可多發。少數瘤體切開時可見膿性物。假瘤邊緣可以不規則或呈鋸齒樣,也可呈分葉狀。CT肺窗圖像上,腫瘤邊緣可清楚地顯示炎性滲出影。長毛刺、與胸膜緊貼或有粘連帶等對本病的診斷具有一定的意義。假瘤術前診斷的主要方法靠X線、CT檢查。胸部正側位相能顯示假瘤的全貌,CT掃描有助於顯示瘤體內部結構(即空洞、鈣化、毛刺、血管、纖維索條影等)。
相關資料
 肺炎性假瘤
肺炎性假瘤肺炎性假瘤在各年齡段均可發病,但主要發生於40歲以後(本組平均年齡51歲),年齡偏大,這可能與肺部多次感染有關。本組病例僅4人有吸菸史(4/16),似與吸菸關係不大,仍需多病例證實。臨床症狀不典型,大部分病人體檢時才意外發現。進一步追問病史,多數患者可詢問出在不同時期有過不同程度的胸悶、胸痛、咳嗽、咳痰,甚至痰中帶血。事實上這些症狀均無特異性,僅在一定程度上提示傾向肺部炎性病變。
肺炎性假瘤在診斷上很難與肺癌、肺結核瘤、錯構瘤等相鑑別 ,這給治療帶來很大的困難。在臨床上,最重要的是與肺癌相鑑別,這直接關係到治療的方法及手術切除的範圍。從病史上看,炎性假瘤患者年齡一般較輕,多無長期吸菸史,全身情況多無明顯變化,可有一過性發熱史,無持續的痰中帶血,無肺外症狀;從影像學上看,炎性假瘤一般位於肺的周邊,呈孤立腫塊影,也可呈多發病灶,大小不等,腫塊密度多均勻,可有鈣化、空洞,但這種情況少見(3例見鈣化,1例見空洞);大部分病例腫塊周圍可見斑點狀影(11/16);縱隔淋巴結腫大(2/16)並不能肯定腫塊就是癌,我們曾遇到1例術中見肺門及縱隔淋巴結增大變硬,考慮為惡性腫瘤,未再做快速病理切片即行肺葉切除和淋巴結清掃,最後病理證實為炎性假瘤,淋巴結增大病理示反應性增生,應引起注意。肺癌的腫塊多呈分葉狀,邊緣毛糙不光滑,密度不均勻,壞死區密度更低,這可能與腫瘤組織生長較活躍有關,可伴胸腔積液,肺門及縱隔淋巴結轉移較多。肺親腫瘤放射性核素顯像檢查對於判定腫塊性質有一定幫助,陰性可大致排除腫瘤(16例病人均呈陰性),但陽性病人確定腫瘤要謹慎,大約有10%的病人可出現假陽性 。通過以上幾點,可大致判定腫塊的性質。實際上,臨床要準確判定腫塊的性質以決定是否手術還是很困難,肺炎性假瘤可出現邊緣不整、毛刺甚至分葉;而肺癌也可出現鈣化、空洞。有人主張對這類病人行動態觀察,如病變縮小甚至消失,則保守治療,否則就積極手術治療。一般認為這種治療時間不宜超過4周。實際上,這樣做意義不大,因為肺炎性假瘤的形成是一個較長的慢性過程,一旦形成,抗炎治療極少能起作用,除非假瘤未完全形成。筆者遇到的病例中,僅有1 例經抗炎等治療後肺癌腫塊影消失。經胸壁 腫塊穿刺活檢及經纖維支氣管鏡活檢對鑑別診斷意義不大。正因為肺炎性假瘤很難與肺癌鑑別,而且,有報導約1.3%的炎性假瘤可變成瘢痕癌或腺癌,再加上一般患者發現患上此病,思想顧慮重,事實上大部分病人均接受了手術。有作者認為腫塊直徑大於3.5cm,CT值超過32Hu則有絕對手術指征,短期治療(4周)無效也應及早手術。在沒有絕對把握的情況下,主張行單純病灶切除或胸腔鏡下病灶切除。胸腔鏡手術損傷小,恢復快,可保留較多的有功能的肺組織,是一種較好的方法。術中強調冰凍快速病理切片檢查,以進一步確診。本組16例病人中有13例套用胸腔鏡手術切除,術後恢復良好。
關注健康,了解疾病
| 2008年5月31日是世界衛生組織發起的第21個世界無菸日。本次無煙主題是“無煙青少年”,口號是“禁止菸草廣告和促銷,確保無煙青春好年華”。讓我們一起拒絕菸草,關注呼吸健康,了解呼吸疾病。 |

